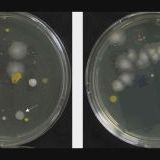

「マスク」の検索結果
2,552件中201-250
-
![]()
63コメント2023/12/05(火) 14:28
X(旧Twitter)でリンク先の見出しが復活するとイーロン・マスクが発言
-
![]()
176コメント2023/12/06(水) 13:15
どんなマスクを付けていますか?
-
![]()
70コメント2023/11/28(火) 22:51
マスクかぶれ防止
-
![]()
40コメント2023/11/21(火) 22:45
サロン勤務の方、まだマスクしてますか?
-
![]()
69コメント2023/11/22(水) 09:52
マスクでも毛穴落ちしないベースメイク
-
![]()
62コメント2023/11/20(月) 00:28
日勤と夜勤でマスクの色分け、残業時間が大幅減…「はよ帰り」「おつかれさま」など声かけやすく
-
![]()
1574コメント2023/11/21(火) 20:01
マスクしている人多くないですか?
-
![]()
105コメント2023/11/15(水) 17:30
マスク拒否男が最高裁に上告、2審も有罪の判決に不服
-
![]()
57コメント2023/11/16(木) 00:42
美白に効いたシートマスク
-
![]()
186コメント2023/11/24(金) 19:02
イーロン・マスク氏、X(旧Twitter)の「ハッシュタグ廃止」を検討。日本のユーザーは賛否両論
-
![]()
356コメント2023/11/19(日) 04:05
「マスク」ほとんどしなくなった…でもマスクは毎日交換すべき? マスクの外側に、糞便の中にいる「セレウス菌」検出のケースも
-
![]()
129コメント2023/11/05(日) 19:44
コロナ禍でマスク売りさばいて年商22億円!ランボルギーニ乗ってタワマン住むも3年で倒産【コロナで味わった天国と地獄】
-
![]()
531コメント2023/11/04(土) 08:05
マスクなしでクシャミや咳をされると感染させられた気分になる
-
![]()
257コメント2023/11/13(月) 21:21
“マスク拒否おじさん”ピーチ機内で客室乗務員に暴行し運航妨害… 奥野淳也被告の控訴棄却 2審も執行猶予付き判決 言い渡し後「おかしい!」と裁判長に詰め寄る場面も 大阪高裁
-
![]()
386コメント2023/10/29(日) 16:56
Xは来年「本格的」出会い系アプリに、マスク氏が社内で表明-報道
-
![]()
427コメント2023/11/04(土) 12:03
倉田真由美さん、観覧者全員マスク着用のテレビ番組に「この異様な状態を続ける理由は何なのか」「薄ら寒くなる」
-
![]()
158コメント2023/11/09(木) 20:55
イーロン・マスク氏 「X」に新たに2つの料金プラン追加へ
-
![]()
874コメント2023/11/15(水) 10:50
最近マスクつけてますか?
-
![]()
191コメント2023/10/23(月) 18:59
木下博勝医師、患者にマスク着用を呼びかけ…まさかの展開「逆ギレされる方がいる」医療現場の現状に嘆き
-
![]()
220コメント2023/10/23(月) 10:36
マスク外した方が綺麗だと言われる人
-
![]()
1866コメント2023/11/09(木) 01:19
母は恐怖を覚えた。マスクを「絶対外したくない」子どもたち。女子に多い“意外な理由”も
-
![]()
154コメント2023/10/17(火) 12:30
【愛用】マスクを語る【今更】
-
![]()
194コメント2023/10/10(火) 19:23
X「返信・リポスト・いいね」の数を非表示に マスクが宣言
-
![]()
87コメント2023/10/08(日) 18:02
イーロン・マスク、元恋人グライムスから子供達3人の親権をめぐり提訴される
-
![]()
511コメント2023/10/20(金) 13:23
51歳「globe」KEIKO、マスクなしの近影に騒然「久しぶりに見た」「きれい」くも膜下出血で療養
-
![]()
106コメント2023/10/20(金) 10:29
効果のあったヘアマスクヘアパック
-
![]()
245コメント2023/10/21(土) 06:17
マスクが楽すぎて手放せない
-
![]()
115コメント2023/09/30(土) 22:27
イーロン・マスクのニューラリンク、脳インプラントチップの初の人体臨床試験に参加者募集
-
![]()
191コメント2023/10/05(木) 10:53
接客業で働く方のマスク
-
![]()
182コメント2023/09/13(水) 13:16
イーロン・マスク、11人目の子どもが生まれていたことが発覚 元カノのグライムスとの間に第3子
-
![]()
180コメント2023/09/14(木) 14:51
「警察に言われて着けるはずがない」取調室でもマスク着用拒否…“マスク拒否おじさん”の逮捕中に起こっていたこと《ピーチ機緊急着陸事件》
-
![]()
1637コメント2023/09/29(金) 08:40
ノーマスクだったけどコロナに罹ってやっぱりマスクつけ始めた人!
-
![]()
160コメント2023/10/03(火) 21:11
マスクを外した自分に自信がない… それ「醜形恐怖症」かも!? 医師が分かりやすく解説
-
![]()
926コメント2023/10/04(水) 22:32
【マスク美人】外した後の反応【マスクイケメン】
-
![]()
65コメント2023/09/09(土) 20:22
ガリットチュウ福島善成 競技開始3年目で柔術世界一 次なる標的はマスク氏「勝ったらX社を福島のF社に」
-
![]()
761コメント2023/09/29(金) 17:08
コロナ禍明け マスク着用は個人の判断となったが…マスクトラブルは現在も起きていた!
-
![]()
288コメント2023/09/26(火) 23:22
Netflix「マスクガール」見てる人
-
![]()
119コメント2023/08/30(水) 12:01
【脱マスク】口臭対策
-
![]()
2506コメント2023/09/17(日) 08:48
今でもマスク一日中つけてるのっておかしい?
-
![]()
808コメント2023/09/08(金) 14:22
Xがブロック機能を廃止へ 「意味がない」とマスク
-
![]()
52コメント2023/08/21(月) 01:18
出会いの場でのマスク問題
-
![]()
353コメント2023/08/14(月) 22:09
有吉弘行、酸素マスク?つけベッドに横たわる写真公開「そういうことなんでひとつよろしく」
-
![]()
108コメント2023/08/18(金) 01:42
マスク取ったら誰だか思い出せない
-
![]()
115コメント2023/08/23(水) 09:44
イーロン・マスク氏投稿の写真に日本ユーザー反応「なんの予告だ?」様々な憶測広がる
-
![]()
249コメント2023/08/17(木) 23:53
「ノーマスクは異常」の色眼鏡あった…マスク拒否男、控訴審で裁判官批判
-
![]()
54コメント2023/08/22(火) 09:05
X(旧Twitter)への投稿で雇用トラブルになった場合は訴訟費用の支援を行うとイーロン・マスクが発表
-
![]()
458コメント2023/08/12(土) 16:14
甘いマスクの大学生が“月額20万円ママ活”をあきらめた理由「キス以上を求めてきたんです」
-
![]()
73コメント2023/08/06(日) 01:20
中野美奈子、コロナ禍でマスク生活終わり「歯が伸びた」 歯医者からの指摘に驚き
-
![]()
121コメント2023/08/07(月) 08:10
シートマスクのおすすめ【夏】
-
![]()
445コメント2023/08/22(火) 09:13
大谷翔平、米サイトでテイラー・スウィフトの恋人候補に浮上 ライバルはドレイク、ブラピ、イーロン・マスク氏